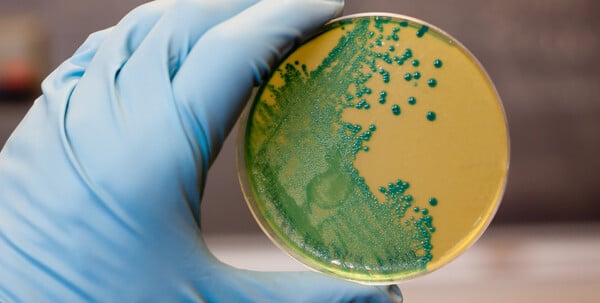
Τι συμβαίνει στις ΗΠΑ με την επιδημία λιστέριας – Ανακαλούνται έτοιμα γεύματα ζυμαρικών

Η επιδημία λιστέριας που συνδέεται με έτοιμα γεύματα ζυμαρικών στις Ηνωμένες Πολιτείες εξαπλώνεται, με τουλάχιστον έξι νεκρούς και 27 ασθενείς σε 18 πολιτείες, ανακοίνωσαν οι ομοσπονδιακές υγειονομικές αρχές.
Το Κέντρο Ελέγχου και Πρόληψης Νοσημάτων (CDC) επιβεβαίωσε ότι δύο ακόμη άνθρωποι πέθαναν και επτά αρρώστησαν τις τελευταίες εβδομάδες, ενώ η πιο πρόσφατη λοίμωξη καταγράφηκε στις 16 Οκτωβρίου. Μεταξύ των θυμάτων περιλαμβάνεται και μια έγκυος γυναίκα που έχασε το έμβρυό της.
Οι νέοι θάνατοι καταγράφηκαν στη Χαβάη και στο Όρεγκον, ενώ οι προηγούμενοι είχαν σημειωθεί σε Ιλινόι, Μίσιγκαν, Τέξας και Γιούτα.
Η πηγή της επιδημίας
Οι ερευνητές εντόπισαν την πηγή της μόλυνσης σε προμαγειρεμένα ζυμαρικά που παρήγαγε η εταιρεία Nate’s Fine Foods, με έδρα την Καλιφόρνια.
Η εταιρεία είχε ανακαλέσει πάνω από 245.000 κιλά προϊόντων, όπως λιγκουίνι, φετουτσίνι, πένες και άλλους τύπους ζυμαρικών, που χρησιμοποιήθηκαν σε έτοιμα γεύματα και σαλάτες διανεμημένα σε ολόκληρη τη χώρα.
Οι αναλύσεις DNA αποκάλυψαν ότι το στέλεχος της λιστέριας που εντοπίστηκε στα προϊόντα της Nate’s ταυτίζεται με αυτό που βρέθηκε σε μολυσμένα γεύματα “Chicken Fettuccine Alfredo” και “Meatball Linguine” που παρήγαγε η εταιρεία FreshRealm για μεγάλες αλυσίδες σούπερ μάρκετ, όπως Walmart και Trader Joe’s.
Οι αρχές καλούν το κοινό να ελέγξει τα ψυγεία και τους καταψύκτες του, να απορρίψει αμέσως ή να επιστρέψει στα καταστήματα οποιοδήποτε προϊόν έχει ανακληθεί, ακόμα κι αν φαίνεται ή μυρίζει φυσιολογικά.
Η λιστέρια μπορεί να προκαλέσει σοβαρές ή θανατηφόρες λοιμώξεις, ιδιαίτερα σε έγκυες γυναίκες, νεογνά, ηλικιωμένους και άτομα με εξασθενημένο ανοσοποιητικό.
Τα συμπτώματα περιλαμβάνουν πυρετό, μυαλγίες, ναυτία και διάρροια και μπορεί να εμφανιστούν μέχρι και δύο μήνες μετά την κατανάλωση μολυσμένου προϊόντος.
Τα προϊόντα που ανακαλούνται
Ανάμεσα στα επώνυμα προϊόντα που αποσύρονται βρίσκονται:
- Trader Joe’s Cajun Style Blackened Chicken Fettuccine Alfredo
- Home Chef Chicken Fettuccine Alfredo
- Scott & Jon’s Shrimp Scampi with Linguini
- Kroger και Giant Eagle deli pasta salads
- Marketside Linguine with Meatballs & Marinara
- Albertsons store-made deli pasta salads
Η έρευνα συνεχίζεται
Το CDC συνεργάζεται με τον Οργανισμό Τροφίμων και Φαρμάκων (FDA), το Υπουργείο Γεωργίας (USDA) και τις πολιτειακές αρχές για να διαπιστωθεί αν έχουν μολυνθεί και άλλα τρόφιμα.
Οι ειδικοί υπενθυμίζουν ότι το βακτήριο Listeria monocytogenes μπορεί να επιβιώσει και να πολλαπλασιαστεί ακόμα και σε χαμηλές θερμοκρασίες, γεγονός που αυξάνει τον κίνδυνο για έτοιμα προϊόντα που φυλάσσονται στο ψυγείο.
Με πληροφορίες από CNN